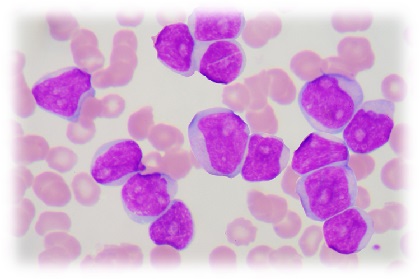

Beta talassemia: studio clinico dimostra sicurezza ed efficacia della terapia genica
La terapia genica, soprattutto se somministrata in giovane età, potrebbe costituire una strategia di cura efficace per la beta talassemia, una malattia genetica molto diffusa nell’area mediterranea e che conta oltre 7000 pazienti solo in Italia. È questo il risultato del primo trial clinico di terapia genica per la beta talassemia realizzato sia in pazienti adulti che pediatrici, frutto di oltre dieci anni di lavoro del gruppo di ricerca di Giuliana Ferrari, docente dell’Università Vita-Salute San Raffaele, all’Istituto San Raffaele Telethon per la Terapia Genica di Milano e possibile grazie all’alleanza strategica tra IRCCS Ospedale San Raffaele, Fondazione Telethon e Orchard Therapeutics.
Lo studio, pubblicato su Nature Medicine, è stato svolto grazie alla sinergia tra ricercatori di base e clinici, e in collaborazione tra l’Unità Operativa di Immunoematologia Pediatrica e quella di Ematologia e Trapianto di Midollo dell’Ospedale San Raffale, dirette rispettivamente da Alessandro Aiuti e Fabio Ciceri, insieme al Centro malattie rare diretto da Maria Domenica Cappellini del Policlinico di Milano. Lo studio, con il coordinamento clinico della dottoressa Sarah Marktel, si è avvalso della partecipazione di altri centri italiani esperti di talassemia e della collaborazione con associazioni dei pazienti, in particolare dell’Associazione Talassemici Drepanocitici Lombardi Onlus (ATDL), che ha favorito il dialogo nella comunità dei pazienti grazie a un percorso ad hoc che ha previsto anche diversi eventi di informazione pubblica e un contributo attivo alla stesura del consenso informato.
La beta talassemia è una malattia genetica del sangue causata da una mutazione del gene che codifica per la beta-globina, componente della emoglobina che è una proteina fondamentale per il funzionamento dei globuli rossi e in particolare per il trasporto dell’ossigeno. Esistono oltre 300 mutazioni note di questo gene, che possono dare origine a forme di beta talassemia di diversa gravità. Le mutazioni più gravi causano una quasi totale assenza della proteina nel sangue dei pazienti, che per sopravvivere devono ricorrere a frequenti trasfusioni, con una riduzione drammatica della qualità della vita, o al trapianto di midollo osseo da donatore.Lo studio ha coinvolto 9 soggetti di diversa età – 3 adulti sopra i trent’anni, 3 adolescenti e 3 bambini sotto i sei anni di età – tutti con forme di beta talassemia gravi da renderli trasfusione dipendenti. I ricercatori hanno utilizzato una tecnica di terapia genica simile a quella già impiegata all’SR-Tiget per altre malattie rare del sangue, come ADA-SCID (il cui trattamento è diventato il primo farmaco salva-vita di terapia genica approvato al mondo), la leucodistrofia metacromatica (MLD) e la sindrome di Wiskott-Aldrich (WAS).
Il protocollo prevede innanzitutto la raccolta delle cellule staminali dal sangue periferico dei pazienti. Per ristabilire il corretto funzionamento di queste cellule e dei globuli rossi in cui possono differenziarsi, i ricercatori hanno quindi inserito al loro interno una copia funzionante del gene della beta-globina, utilizzando un cosiddetto vettore lentivirale: virus della stessa famiglia dell’HIV, svuotato del suo contenuto infettivo e trasformato in vero e proprio mezzo di trasporto per la terapia. Infine le cellule staminali corrette sono state re-infuse nei pazienti direttamente nelle ossa, così da favorire il loro attecchimento nel midollo osseo. A distanza di oltre un anno dal trattamento (i soggetti adulti sono stati trattati per primi, ormai quasi 3 anni fa) la terapia risulta sicura ed efficace: in 3 dei 4 pazienti più giovani con un follow-up sufficiente per la valutazione si è raggiunta la totale indipendenza dalle trasfusioni di sangue, mentre nei tre pazienti adulti si è ottenuta una significativa riduzione della loro frequenza. Solo uno dei bambini trattati non ha riportato effetti positivi sul decorso della malattia e i ricercatori stanno ora cercando di capirne il motivo.
«È la prima volta che la terapia genica per la beta talassemia viene utilizzata in pazienti pediatrici. I risultati raccolti fino ad ora dimostrano non solo la sua sicurezza in questo contesto, ma anche la sua maggiore efficacia», spiega Giuliana Ferrari. «Dal momento che la malattia compromette in modo progressivo l’integrità del midollo osseo, intervenire in giovane età permette di ottenere risultati migliori». Oltre al fattore età, un altro elemento chiave è l’efficienza del “trasferimento genico”, ovvero la capacità dei vettori virali di inserire con successo nelle cellule dei pazienti il gene terapeutico. «In patologie complesse come la beta talassemia può giocare un ruolo importante, ecco perché la messa a punto di protocolli innovativi, capaci di massimizzare l’efficacia dei vettori, è una delle nostre priorità», conclude Giuliana Ferrari.